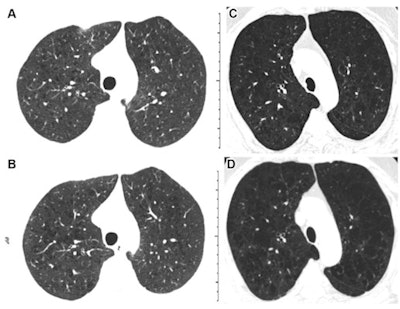

A deep-learning algorithm helps clinicians assess the progression of emphysema in cigarette smokers at five-year follow-up after baseline CT, according to a study published May 17 in Radiology.
The results shed light on how the disease progresses over time, wrote a team led by Dr. Andrea Oh of National Jewish Health in Denver, CO.
"Using a previously validated computer algorithm for automatic grading of emphysema pattern according to the Fleischner Society criteria, we demonstrated that an increase in emphysema grade on sequential CT scans is associated with substantial disease progression and increased risk of mortality," the group noted.
Evaluating emphysema on CT is typically done via visual assessment of the images -- a process that can be time-consuming and affected by reader variability, the group noted. Oh and colleagues investigated whether a deep-learning algorithm could help clinicians better evaluate emphysema progression at five-year follow-up CT.
To this end, they conducted an analysis that included 5,056 participants in the Genetic Epidemiology of Chronic Obstructive Pulmonary Disease (COPDGene) study who were current and former smokers and had undergone baseline and follow-up CT scans between 2007 and 2017. The presence of emphysema on CT was measured at the initial exams by the Fleischner grading system (which ranges from 0, or absent, to 5, or "advanced destructive") and at five-year follow-up exams by a deep-learning model developed and validated with Python and PyTorch.
"Our purpose was to evaluate the significance of increased emphysema severity, as graded by a deep learning algorithm on sequential CT scans according to the Fleischner Society emphysema classification system in cigarette smokers," Oh's group explained.
Of the total cohort, 26% had Fleischner emphysema scores that had increased by one or more categories at five-year follow-up, progression which manifested in more airflow obstruction and shortness of breath compared with baseline assessment, shorter six-minute walk distances, greater extent of disease, and lower quality of life. (Increased Fleischner emphysema grade on follow-up is associated with a higher mortality rate, the team noted.)
The study suggests that using deep learning with CT to track emphysema progression could both improve clinicians' understanding of the disease and reduce interpretation time and variability, according to the group.
"The deep-learning technique used in our study mitigates [the limits of visual scoring] by automating image classification, which effectively eliminates the time burden and subjectivity of visual assessment," Oh and colleagues concluded. "Moreover, the trained algorithm embodies the expert knowledge of the Fleischner scoring system, potentially allowing for distribution of the criteria at a global level and use as a training aid to foster wider adoption."